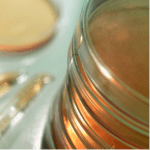
stack-of-petri-dishes

Although many lactation specialists agree that breasts are susceptible to thrush (the candida fungus) when a woman is nursing, others feel that the yeast infection is ‘overdiagnosed and overtreated1.’ A quick perusal of the Mumsnet discussion forum shows that some health professionals are prepared to go a step further, and deny it is a problem at all (see breastfeeding and thrush: it’s complicated).
Although many lactation specialists agree that breasts are susceptible to thrush (the candida fungus) when a woman is nursing, others feel that the yeast infection is ‘overdiagnosed and overtreated1.’ A quick perusal of the Mumsnet discussion forum shows that some health professionals are prepared to go a step further, and deny it is a problem at all (see breastfeeding and thrush: it’s complicated).
The scepticism that thrush can interfere with breastfeeding exists because at present there is no absolute proof that candida is the root cause of breastfeeding pain. A mother can become colonized with candida but remain infection-free, or can display many of the symptoms commonly associated with thrush (such as red, shiny, flaky or burning nipples) but test negative for it in the laboratory2.
This doesn’t mean that thrush isn’t a problem however: there are several controlled clinical studies that point to an association – not a perfect one, but a significant one nonetheless – between the presence of candida and certain symptoms suffered by breastfeeding mothers.
Evidence that thrush can affect breastfeeding mothers
Support for this relationship was provided by a study that assessed whether mothers who tested positive for candida shortly after they had given birth went on to develop the symptoms of thrush2,3. Nipple swabs and milk samples that were taken from 100 women at their two week post-birth check underwent microbiologic culturing to test for candida, and women completed two interviews to determine whether they had symptoms associated with thrush: one at the time the swabs were taken, and another 7 weeks later.
Although there was no association between colonization and symptoms initially, 20 of the 23 women colonized by candida went on to develop at least one of the symptoms of thrush (burning nipples, stabbing breast pain, shiny and/or red nipples). The percentage of cases (breasts rather than mothers, as it’s possible to be affected on only one side) with a positive or negative candida result that developed symptoms are listed below.
Nipple culture results (22 positive cases, 178 negative cases):
- 95% of positive cases and 49% of negative cases reported sore nipples
- 100% of positive cases and 33% of negative cases reported burning nipples
- 82% of positive cases and 18% of negative cases reported non-stabbing breast pain
- 91% of positive cases and 24% of negative cases reported stabbing breast pain
- 45% of positive cases and 11% of negative cases reported shiny nipples
- 36% of positive cases and 13% of negative cases reported flaky nipples
Milk culture results (32 positive cases, 168 negative cases):
- 78% of positive cases and 50% of negative cases reported sore nipples
- 81% of positive cases and 33% of negative cases reported burning nipples
- 72% of positive cases and 16% of negative cases reported non-stabbing breast pain
- 81% of positive cases and 21% of negative cases reported stabbing breast pain
- 41% of positive cases and 10% of negative cases reported shiny nipples
- 38% of positive cases and 11% of negative cases reported flaky nipples
Every symptom occurred at a significantly higher rate in the cases where candida had been detected. Each symptom was also reported in several negative cases, however, indicating either that the mothers had become colonized by candida after the initial test, or that the symptoms were caused by something else.
Another study investigating the link between the results of milk cultures and breastfeeding pain also reported that candida was found in a significantly greater proportion of women who were suffering from sharp, shooting breast pain: 6/20 (30%) of the women with pain tested positive for it, but only 6/78 (5%) of the no pain group4. This study also tested for levels of common bacteria, and found they did not differ significantly between the two groups.
Evidence that symptoms associated with thrush may be caused by something else
There are other experiments, however, which indicate that bacteria – rather than fungi – may be the culprit in some occurrences of breastfeeding pain. A study comparing culture results of 20 women with deep, stabbing pain, 20 with superficial nipple pain and 20 controls with no pain found an association between candida and superficial pain, and bacteria and deep pain: candida was found on the nipples of 1 of the control group, 12 of the superficial pain group and 10 of the deep pain group; and in the milk of 1 of the control group, 10 of the superficial pain group and 5 of the deep pain group5. By contrast, pathogenic bacteria were detected on the nipples of 4 of the control group, 11 of the superficial pain group and 19 of the deep pain group, and in the milk of 6 of the control group, 8 of the superficial pain group and 14 of the deep pain group.
Support for the idea that thrush does not underlie all breastfeeding pain is also provided by a recent study that compared levels of candida in the milk of 18 healthy breastfeeding mothers and 16 with thrush symptoms (sore, inflamed or traumatized nipples, intense stabbing or burning pain and painful breastfeeding that had not received any other diagnosis)6. The investigators were very careful to avoid contamination of the sample: nipples were thoroughly washed, and breasts were pumped for 12 minutes before any milk was collected. No evidence of candida was found in any of the samples, leading the authors to suggest that it does not infect milk ducts, and is unlikely to be the cause of the symptoms associated with thrush. They also go a step further, and suggest that positive nipple cultures cannot be trusted, as they may be contaminated by the baby’s saliva, which often contains candida. They conclude that, ‘candida infection on the mother’s skin remains a possibility, but it seems unlikely.’
This interpretation of the results seems fairly extreme. In previous studies, candida has been found to colonize milk (but not nipples)2 so the possibility that thrush may infect milk ducts cannot be ruled out. It is also not really appropriate to draw conclusions from the data about candida infection of the nipple, or the role of bacteria in breast pain, as neither of these things was actually examined. There is some evidence that bacteria may underlie certain instances of breast pain – it has been found at higher concentrations than candida in the milk of women suffering from deep pain5 – but this result conflicts with another reporting higher levels of candida in women suffering from a similar complaint4.
It is not only the role of bacteria that is hazy, however: despite the association between candida and symptoms reported in some studies, this link is far from concrete. Not every woman with the symptoms of thrush tests positive for candida, and some who are colonized by it never report symptoms. If you also consider that cultures themselves can be easily contaminated and may therefore be unreliable, the picture gets even more complicated.
Treating the symptoms of thrush
What does all this mean for breastfeeding women who appear to be suffering from thrush? Some researchers take the view that as the relationship isn’t sufficiently proven, women should not be treated with antifungal medication, or should receive it only as part of a controlled trial7. Others take a more pragmatic view, and suggest that such medication can actually have a useful diagnostic value: if the symptoms clear up after using an antifungal, then this ‘confirms’* that the symptoms were caused by candida8. This is far from an ideal solution (using such medications unnecessarily is expensive and increases the chances of fungi developing resistance to them), but it may be preferable to leaving women to suffer with very painful symptoms when there is chance they could be cured. Women who exhibit the symptoms of thrush when breastfeeding are at a very high risk of giving up3, so if there’s a medication that could stop this from happening, it may not be a bad idea to use it.
- Breastfeed Med. 2009 Jun;4(2):55.
- J Hum Lact. 2004 Aug;20(3):288-95.
- J Obstet Gynecol Neonatal Nurs. 2005 Jan-Feb;34(1):37-45.
- Am J Obstet Gynecol. 2007 Oct;197(4):424.e1-4.
- Gynecol Obstet Invest. 1998 Aug;46(2):73-4.
- Breastfeed Med. 2009 Jun;4(2):57-61
- Breast. 2002 Feb;11(1):88-90
- J Hum Lact. 1999 Dec;15(4):281-8.
*Of course, this doesn’t really confirm that a mother was suffering from thrush, as the alleviation of her symptoms may have been coincidental.
 Maintaining a slightly damp, rather than dry, environment under a dressing has been shown in many studies to help wounds heal faster. Moisture prevents a scab from forming, which allows new
Maintaining a slightly damp, rather than dry, environment under a dressing has been shown in many studies to help wounds heal faster. Moisture prevents a scab from forming, which allows new  Up to 90% of women experience nipple pain or soreness in the initial stage of breastfeeding, with the pain peaking in the first week, then gradually subsiding
Up to 90% of women experience nipple pain or soreness in the initial stage of breastfeeding, with the pain peaking in the first week, then gradually subsiding There are many substances said to prevent or relieve nipple pain and damage during the early days of breastfeeding, including
There are many substances said to prevent or relieve nipple pain and damage during the early days of breastfeeding, including  When I suffered substantial nipple damage in the early weeks of breastfeeding, the ‘moist wound healing’ route didn’t prove effective (see
When I suffered substantial nipple damage in the early weeks of breastfeeding, the ‘moist wound healing’ route didn’t prove effective (see 